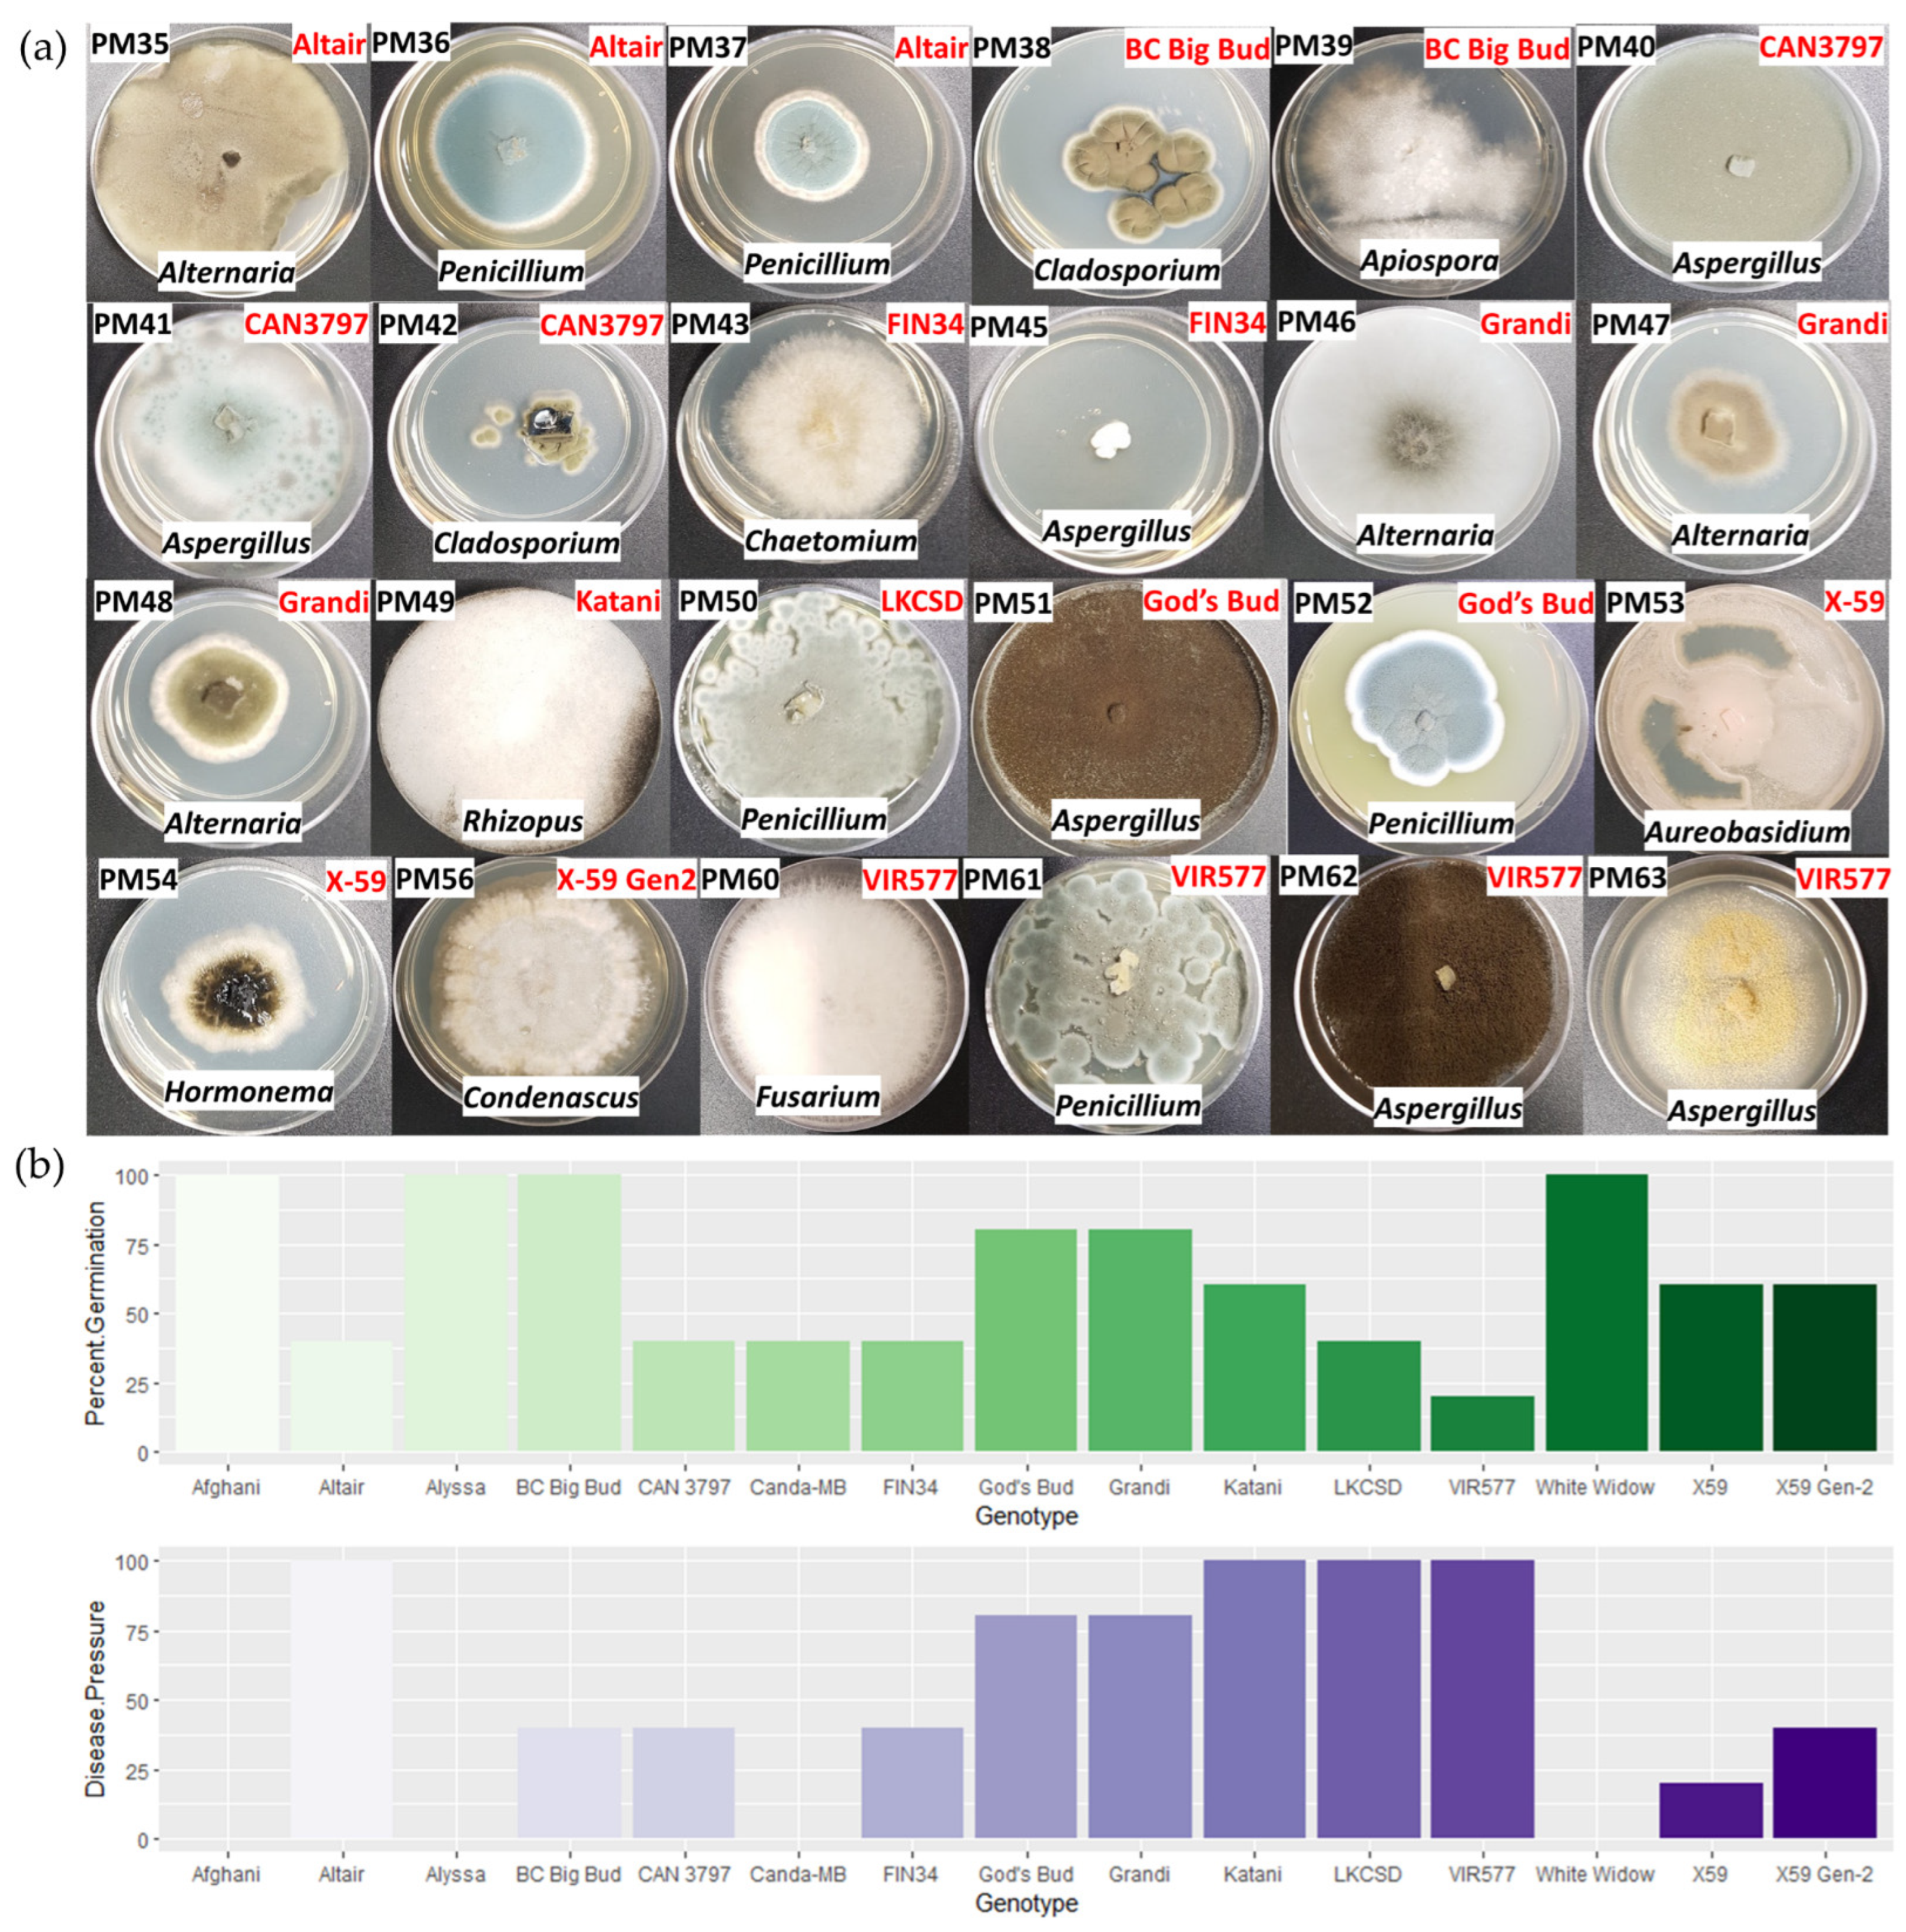
Plants 11 02127 g004 550

Cannabis Seedlings Inherit Seed-Borne Bioactive and Anti-Fungal Endophytic Bacilli
Abstract
:1. Introduction
2. Results
2.1. Cannabis Seedlings Inherit Seed-Borne Endophytic Bacilli
2.2. Endophyte Phosphate Solubilization
2.3. Endophyte Indole-3-Acetic Acid Activity
2.4. Endophyte Pectinase Activity
2.5. Seed-Borne Fungi
2.6. Endophyte Anti-Fungal Activity
3. Discussion
4. Materials and Methods
4.1. Source of Seed
4.2. Seed-Borne Cannabis Seedling Endophyte Isolation
4.3. Taxonomic Identification by 16S Gene Sequencing
4.4. Phosphate Solubilization Assay
4.5. Pectinase Activity
4.6. IAA Secretion
4.7. Seed-Borne Fungi from Cannabis Culturing
4.8. Anti-Fungal Activity of Cannabis Endophytes
Supplementary Materials
Author Contributions
Funding
Institutional Review Board Statement
Informed Consent Statement
Data Availability Statement
Acknowledgments
Conflicts of Interest
References
- Johnston-Monje, D.; Raizada, M.N. Plant and Endophyte Relationships: Nutrient Management; Elsevier: Amsterdam, The Netherlands, 2011; Volume 1, ISBN 9780080885049. [Google Scholar]
- Shehata, H.R.; Dumigan, C.; Watts, S.; Raizada, M.N. An Endophytic Microbe from an Unusual Volcanic Swamp Corn Seeks and Inhabits Root Hair Cells to Extract Rock Phosphate. Sci. Rep. 2017, 7, 13479. [Google Scholar] [CrossRef] [PubMed]
- Hu, C.; Reddy, M.S.; Wei, H.; Pare, P.W.; Greer, J.; Wu, J.Y.; Ornitz, D.M.; Yuan, W.; Rao, Y.; Babiuk, R.P.; et al. Bacterial Volatiles Promote Growth in Arabidopsis. Proc. Natl. Acad. Sci. USA 2003, 100, 4927–4932. [Google Scholar]
- Mousa, W.K.; Shearer, C.; Limay-Rios, V.; Ettinger, C.L.; Eisen, J.A.; Raizada, M.N. Root-Hair Endophyte Stacking in Finger Millet Creates a Physicochemical Barrier to Trap the Fungal Pathogen Fusarium Graminearum. Nat. Microbiol. 2016, 1, 16167. [Google Scholar] [CrossRef] [PubMed]
- Berg, G.; Martina, K.; Rybakova, D.; Henry, M.; Grosch, R.; Smalla, K. Plant Microbial Diversity Is Suggested as the Key to Future Biocontrol and Health Trends. FEMS Microbiol. Ecol. 2017, 93, fix050. [Google Scholar] [CrossRef]
- Khalaf, E.M.; Raizada, M.N. Bacterial Seed Endophytes of Domesticated Cucurbits Antagonize Fungal and Oomycete Pathogens Including Powdery Mildew. Front. Microbiol. 2018, 9, 42. [Google Scholar] [CrossRef]
- Barret, M.; Briand, M.; Bonneau, S.; Préveaux, A.; Valière, S.; Bouchez, O.; Hunault, G.; Simoneau, P.; Jacquesa, M.A. Emergence Shapes the Structure of the Seed Microbiota. Appl. Environ. Microbiol. 2015, 81, 1257–1266. [Google Scholar] [CrossRef]
- Ferreira, A.; Quecine, M.C.; Lacava, P.T.; Oda, S.; Azevedo, J.L.; Araújo, W.L. Diversity of Endophytic Bacteria from Eucalyptus Species Seeds and Colonization of Seedlings by Pantoea Agglomerans. FEMS Microbiol. Lett. 2008, 287, 8–14. [Google Scholar] [CrossRef]
- Nelson, E.B. The Seed Microbiome: Origins, Interactions, and Impacts. Plant Soil 2018, 422, 7–34. [Google Scholar] [CrossRef]
- Shahzad, R.; Khan, A.L.; Bilal, S.; Asaf, S.; Lee, I.J. What Is There in Seeds? Vertically Transmitted Endophytic Resources for Sustainable Improvement in Plant Growth. Front. Plant Sci. 2018, 9, 24. [Google Scholar] [CrossRef]
- van Overbeek, L.S.; Franke, A.C.; Nijhuis, E.H.M.; Groeneveld, R.M.W.; da Rocha, U.N.; Lotz, L.A.P. Bacterial Communities Associated with Chenopodium Album and Stellaria Media Seeds from Arable Soils. Microb. Ecol. 2011, 62, 257–264. [Google Scholar] [CrossRef]
- Johnston-Monje, D.; Gutiérrez, J.P.; Lopez-Lavalle, L.A.B. Seed-Transmitted Bacteria and Fungi Dominate Juvenile Plant Microbiomes. Front. Microbiol. 2021, 12, 737616. [Google Scholar] [CrossRef]
- Bacilio-Jiménez, M.; Aguilar-Flores, S.; Del Valle, M.V.; Pérez, A.; Zepeda, A.; Zenteno, E. Endophytic Bacteria in Rice Seeds Inhibit Early Colonization of Roots by Azospirillum Brasilense. Soil Biol. Biochem. 2001, 33, 167–172. [Google Scholar] [CrossRef]
- Massalha, H.; Korenblum, E.; Malitsky, S.; Shapiro, O.H.; Aharoni, A. Live Imaging of Root-Bacteria Interactions in a Microfluidics Setup. Proc. Natl. Acad. Sci. USA 2017, 114, 4549–4554. [Google Scholar] [CrossRef]
- Hardoim, P.R.; Hardoim, C.C.P.; van Overbeek, L.S.; van Elsas, J.D. Dynamics of Seed-Borne Rice Endophytes on Early Plant Growth Stages. PLoS ONE 2012, 7, e30438. [Google Scholar] [CrossRef]
- Normander, B.; Prosser, J.I. Bacterial Origin and Community Composition in the Barley Phytosphere as a Function of Habitat and Presowing Conditions. Appl. Environ. Microbiol. 2000, 66, 4372–4377. [Google Scholar] [CrossRef]
- Johnston-Monje, D.; Lundberg, D.S.; Lazarovits, G.; Reis, V.M.; Raizada, M.N. Bacterial Populations in Juvenile Maize Rhizospheres Originate from Both Seed and Soil. Plant Soil 2016, 405, 337–355. [Google Scholar] [CrossRef]
- Johnston-Monje, D.; Mousa, W.K.; Lazarovits, G.; Raizada, M.N. Impact of Swapping Soils on the Endophytic Bacterial Communities of Pre-Domesticated, Ancient and Modern Maize. BMC Plant Biol. 2014, 14, 233. [Google Scholar] [CrossRef]
- Pitzschke, A. Developmental Peculiarities and Seed-Borne Endophytes in Quinoa: Omnipresent, Robust Bacilli Contribute to Plant Fitness. Front. Microbiol. 2016, 7, 2. [Google Scholar] [CrossRef]
- Khalaf, E.M.; Raizada, M.N. Taxonomic and Functional Diversity of Cultured Seed Associated Microbes of the Cucurbit Family. BMC Microbiol. 2016, 16, 131. [Google Scholar] [CrossRef]
- New Fronteir Data U.S. Cannabis Report: 2019 Industry Outlook. Available online: https://newfrontierdata.com/product/u-s-cannabis-report-2019-industry-outlook/ (accessed on 1 March 2021).
- Punja, Z.K.; Scott, C.; Chen, S. Root and Crown Rot Pathogens Causing Wilt Symptoms on Field-Grown Marijuana (Cannabis sativa L.) Plants. Can. J. Plant Pathol. 2018, 40, 528–541. [Google Scholar] [CrossRef]
- Punja, Z.K.; Collyer, D.; Scott, C.; Lung, S.; Holmes, J.; Sutton, D. Pathogens and Molds Affecting Production and Quality of Cannabis sativa L. Front. Plant Sci. 2019, 10, 1120. [Google Scholar] [CrossRef]
- Punja, Z.K. First Report of Fusarium Proliferatum Causing Crown and Stem Rot, and Pith Necrosis, in Cannabis (Cannabis sativa L., Marijuana) Plants. Can. J. Plant Pathol. 2020, 43, 236–255. [Google Scholar] [CrossRef]
- Punja, Z.K. Flower and Foliage-Infecting Pathogens of Marijuana (Cannabis sativa L.) Plants. Can. J. Plant Pathol. 2018, 40, 514–527. [Google Scholar] [CrossRef]
- Punja, Z.K. The Diverse Mycoflora Present on Dried Cannabis (Cannabis sativa L., Marijuana) Inflorescences in Commercial Production. Can. J. Plant Pathol. 2020, 43, 88–100. [Google Scholar] [CrossRef]
- McKernan, K.; Spangler, J.; Zhang, L.; Tadigotla, V.; Helbert, Y.; Foss, T.; Smith, D.R. Cannabis Microbiome Sequencing Reveals Several Mycotoxic Fungi Native to Dispensary Grade Cannabis Flowers. F1000Research 2015, 4, 1422. [Google Scholar] [CrossRef]
- Imolehin, E.D. Effect of Fungi on Rice Seed Germination. Plant Dis. 1983, 67, 1334–1336. [Google Scholar] [CrossRef]
- Mitter, B.; Pfaffenbichler, N.; Flavell, R.; Compant, S.; Antonielli, L.; Petric, A.; Berninger, T.; Naveed, M.; Sheibani-Tezerji, R.; von Maltzahn, G.; et al. A New Approach to Modify Plant Microbiomes and Traits by Introducing Beneficial Bacteria at Flowering into Progeny Seeds. Front. Microbiol. 2017, 8, 11. [Google Scholar] [CrossRef]
- Dutta, B.; Gitaitis, R.; Smith, S.; Langston, D. Interactions of Seedborne Bacterial Pathogens with Host and Non-Host Plants in Relation to Seed Infestation and Seedling Transmission. PLoS ONE 2014, 9, e99215. [Google Scholar] [CrossRef]
- Fürnkranz, M.; Lukesch, B.; Müller, H.; Huss, H.; Grube, M.; Berg, G. Microbial Diversity Inside Pumpkins: Microhabitat-Specific Communities Display a High Antagonistic Potential against Phytopathogens. Microb. Ecol. 2012, 63, 418–428. [Google Scholar] [CrossRef]
- Schluttenhofer, C.; Yuan, L. Challenges towards Revitalizing Hemp: A Multifaceted Crop. Trends Plant Sci. 2017, 22, 917–929. [Google Scholar] [CrossRef]
- Maity, A.; Lamichaney, A.; Joshi, D.C.; Bajwa, A.; Subramanian, N.; Walsh, M.; Bagavathiannan, M. Seed Shattering: A Trait of Evolutionary Importance in Plants. Front. Plant Sci. 2021, 12, 1180. [Google Scholar] [CrossRef] [PubMed]
- Spaepen, S.; Vanderleyden, J.; Remans, R. Indole-3-Acetic Acid in Microbial and Microorganism-Plant Signaling. FEMS Microbiol. Rev. 2007, 31, 425–448. [Google Scholar] [CrossRef] [PubMed]
- Spaepen, S.; Vanderleyden, J. Auxin and Plant-Microbe Interactions. Cold Spring Harb. Perspect. Biol. 2011, 3, a001438. [Google Scholar] [CrossRef] [PubMed]
- Bric, J.M.; Bostock, R.M.; Silverstone, S.E. Rapid in Situ Assay for Indoleacetic Acid Production by Bacteria Immobilized on a Nitrocellulose Membrane. Appl. Environ. Microbiol. 1991, 57, 535–538. [Google Scholar] [CrossRef]
- Wang, J.; Wei, X.; Kamran, M.; Chen, T.; White, J.F.; Li, C. Quality and Nutrition of Oat Seed as Influenced by Seed-Borne Fungal Pathogens during Storage. J. Plant Dis. Prot. 2022, 129, 243–252. [Google Scholar] [CrossRef]
- Verma, S.K.; Kingsley, K.L.; Bergen, M.S.; Kowalski, K.P.; White, J.F. Fungal Disease Prevention in Seedlings of Rice (Oryza sativa) and Other Grasses by Growth-Promoting Seed-Associated Endophytic Bacteria from Invasive Phragmites Australis. Microorganisms 2018, 6, 21. [Google Scholar] [CrossRef]
- Moroenyane, I.; Tremblay, J.; Yergeau, E. Soybean Microbiome Recovery after Disruption Is Modulated by the Seed and Not the Soil Microbiome. Phytobiomes J. 2021, 5, 418–431. [Google Scholar] [CrossRef]
- Lundberg, D.S.; Lebeis, S.L.; Paredes, S.H.; Yourstone, S.; Gehring, J.; Malfatti, S.; Tremblay, J.; Engelbrektson, A.; Kunin, V.; Del Rio, T.G.; et al. Defining the Core Arabidopsis Thaliana Root Microbiome. Nature 2012, 488, 86–90. [Google Scholar] [CrossRef]
- Walitang, D.I.; Kim, C.G.; Kim, K.; Kang, Y.; Kim, Y.K.; Sa, T. The Influence of Host Genotype and Salt Stress on the Seed Endophytic Community of Salt-Sensitive and Salt-Tolerant Rice Cultivars. BMC Plant Biol. 2018, 18, 51. [Google Scholar] [CrossRef]
- Johnston-Monje, D.; Raizada, M.N. Conservation and Diversity of Seed Associated Endophytes in Zea across Boundaries of Evolution, Ethnography and Ecology. PLoS ONE 2011, 6, e20396. [Google Scholar] [CrossRef]
- Wills, S.I.M.O. Cannabis Use and Abuse by Man: An Historical Perspective. In Cannabis: The Genus Cannabis; CRC Press: Boca Raton, FL, USA, 1998; pp. 1–27. [Google Scholar]
- Andre, C.M.; Hausman, J.F.; Guerriero, G. Cannabis sativa: The Plant of the Thousand and One Molecules. Front. Plant Sci. 2016, 7, 19. [Google Scholar] [CrossRef]
- Henry, P.; Khatodia, S.; Kapoor, K.; Gonzales, B.; Middleton, A.; Hong, K.; Hilyard, A.; Johnson, S.; Allen, D.; Chester, Z.; et al. A Single Nucleotide Polymorphism Assay Sheds Light on the Extent and Distribution of Genetic Diversity, Population Structure and Functional Basis of Key Traits in Cultivated North American Cannabis. J. Cannabis Res. 2020, 2, 26. [Google Scholar] [CrossRef]
- Mohabeer, A.J.; Kaplan, P.J.; Southern, J.; Gander, R.M. Algaemia Due to Prototheca Wickerhamii in a Patient with Myasthenia Gravis. J. Clin. Microbiol. 1997, 35, 3305–3307. [Google Scholar] [CrossRef]
- Richardson, A.E.; Barea, J.M.; McNeill, A.M.; Prigent-Combaret, C. Acquisition of Phosphorus and Nitrogen in the Rhizosphere and Plant Growth Promotion by Microorganisms. Plant Soil 2009, 321, 305–339. [Google Scholar] [CrossRef]
- Bevan, L.; Jones, M.; Zheng, Y. Optimisation of Nitrogen, Phosphorus, and Potassium for Soilless Production of Cannabis Sativa in the Flowering Stage Using Response Surface Analysis. Front. Plant Sci. 2021, 12, 764103. [Google Scholar] [CrossRef]
- Shiponi, S.; Bernstein, N. The Highs and Lows of P Supply in Medical Cannabis: Effects on Cannabinoids, the Ionome, and Morpho-Physiology. Front. Plant Sci. 2021, 12, 910. [Google Scholar] [CrossRef]
- Lamb, C.; Dixon, R.A. The Oxidative Burst in Plant Disease Resistance. Annu. Rev. Plant Biol. 1997, 48, 251–275. [Google Scholar] [CrossRef]
- Bailly, C.; El-Maarouf-Bouteau, H.; Corbineau, F. From Intracellular Signaling Networks to Cell Death: The Dual Role of Reactive Oxygen Species in Seed Physiology. Comptes Rendus-Biol. 2008, 331, 806–814. [Google Scholar] [CrossRef]
- Ivanchenko, M.G.; Den Os, D.; Monshausen, G.B.; Dubrovsky, J.G.; Bednářová, A.; Krishnan, N. Auxin Increases the Hydrogen Peroxide (H2O2) Concentration in Tomato (Solanum lycopersicum) Root Tips While Inhibiting Root Growth. Ann. Bot. 2013, 112, 1107–1116. [Google Scholar] [CrossRef]
- KrishnaMurthy, A.; Rathinasabapathi, B. Oxidative Stress Tolerance in Plants: Novel Interplay between Auxin and Reactive Oxygen Species Signaling. Plant Signal. Behav. 2013, 8, e25761. [Google Scholar] [CrossRef]
- Chen, C.; Twito, S.; Miller, G. New Cross Talk between ROS, ABA and Auxin Controlling Seed Maturation and Germination Unraveled in APX6 Deficient Arabidopsis Seeds. Plant Signal. Behav. 2014, 9, e976489. [Google Scholar] [CrossRef]
- Verma, S.K.; Kingsley, K.; Irizarry, I.; Bergen, M.; Kharwar, R.N.; White, J.F. Seed-Vectored Endophytic Bacteria Modulate Development of Rice Seedlings. J. Appl. Microbiol. 2017, 122, 1680–1691. [Google Scholar] [CrossRef]
- Scott, M.; Rani, M.; Samsatly, J.; Charron, J.B.; Jabaji, S. Endophytes of Industrial Hemp (Cannabis sativa L.) Cultivars: Identification of Culturable Bacteria and Fungi in Leaves, Petioles, and Seeds. Can. J. Microbiol. 2018, 64, 664–680. [Google Scholar] [CrossRef]
- Kandel, S.L.; Joubert, P.M.; Doty, S.L. Bacterial Endophyte Colonization and Distribution within Plants. Microorganisms 2017, 5, 77. [Google Scholar] [CrossRef]
- Presentato, A.; Piacenza, E.; Scurria, A.; Albanese, L.; Zabini, F.; Meneguzzo, F.; Nuzzo, D.; Pagliaro, M.; Martino, D.C.; Alduina, R.; et al. A New Water-Soluble Bactericidal Agent for the Treatment of Infections Caused by Gram-Positive and Gram-Negative Bacterial Strains. Antibiotics 2020, 9, 586. [Google Scholar] [CrossRef]
- Punja, Z.K. Emerging Diseases of Cannabis sativa and Sustainable Management. Pest Manag. Sci. 2021, 77, 3857–3870. [Google Scholar] [CrossRef]
- Kumar, R.; Gupta, A. Seed-Borne Diseases of Agricultural Crops: Detection, Diagnosis & Management; Springer: Berlin/Heidelberg, Germany, 2020; ISBN 9789813290464. [Google Scholar]
- Roberts, A.J.; Punja, Z.K. Pathogenicity of Seedborne Alternaria and Stemphylium Species and Stem-Infecting Neofusicoccum and Lasiodiplodia Species to Cannabis (Cannabis sativa L., Marijuana) Plants. Can. J. Plant Pathol. 2022, 44, 250–269. [Google Scholar] [CrossRef]
- Ongena, M.; Jacques, P. Bacillus Lipopeptides: Versatile Weapons for Plant Disease Biocontrol. Trends Microbiol. 2008, 16, 115–125. [Google Scholar] [CrossRef]
- Cochrane, S.A.; Verderas, J.C. Lipopeptides from Bacillus and Paenibacillus spp.: A Gold Mine ofAntibiotic Candidates Stephen. Med. Res. Rev. 2014, 36, 4–31. [Google Scholar] [CrossRef]
- Percival, D.C.; Abbey, J.; Lu, H.; Harris, L. Use of Biofungicides to Address Conventional Botrytis Blight Control Challenges in Wild Blueberry Production. Acta Hortic. 2017, 1180, 241–247. [Google Scholar] [CrossRef]
- Matzen, N.; Heick, T.M.; Jørgensen, L.N. Control of Powdery Mildew (Blumeria Graminis spp.) in Cereals by Serenade®ASO (Bacillus amyloliquefaciens (Former Subtilis) Strain QST 713). Biol. Control 2019, 139, 104067. [Google Scholar] [CrossRef]
- Reiss, A.; Jørgensen, L.N. Biological Control of Yellow Rust of Wheat (Puccinia striiformis) with Serenade®ASO (Bacillus subtilis Strain QST713). Crop Prot. 2017, 93, 1–8. [Google Scholar] [CrossRef]
- Abbasi, P.A.; Weselowski, B. Influence of Foliar Sprays of Bacillus Subtilis QST 713 on Development of Early Blight Disease and Yield of Field Tomatoes in Ontario. Can. J. Plant Pathol. 2014, 36, 170–178. [Google Scholar] [CrossRef]
- Lahlali, R.; Peng, G.; McGregor, L.; Gossen, B.D.; Hwang, S.F.; McDonald, M. Mechanisms of the Biofungicide Serenade (Bacillus Subtilis QST713) in Suppressing Clubroot. Biocontrol Sci. Technol. 2011, 21, 1351–1362. [Google Scholar] [CrossRef]
- Jo, E.J.; Kang, B.G.; Jang, K.S.; Choi, Y.H.; Kim, J.-C.; Choi, G.J. Control Efficacy of Serenade Formulation against Rhizoctonia and Pythium Damping-off Diseases. Res. Plant Dis. 2014, 20, 201–205. [Google Scholar] [CrossRef]
- Comeau, D.; Balthazar, C.; Novinscak, A.; Bouhamdani, N.; Joly, D.L.; Filion, M. Interactions between Bacillus spp., Pseudomonas spp. and Cannabis Sativa Promote Plant Growth. Front. Microbiol. 2021, 12, 715758. [Google Scholar] [CrossRef]
- Balthazar, C.; Novinscak, A.; Cantin, G.; Joly, D.L.; Filion, M. Biocontrol Activity of Bacillus spp. and Pseudomonas spp. against Botrytis Cinerea and Other Cannabis Fungal Pathogens. Phytopathology 2022, 112, 549–560. [Google Scholar] [CrossRef]
- Punja, Z.K.; Ni, L. The Bud Rot Pathogens Infecting Cannabis (Cannabis sativa L., Marijuana) Inflorescences: Symptomology, Species Identification, Pathogenicity and Biological Control. Can. J. Plant Pathol. 2021, 43, 827–854. [Google Scholar] [CrossRef]
- Monthony, A.S.; Page, S.R.; Hesami, M.; Jones, A.M.P. The Past, Present and Future of Cannabis Sativa Tissue Culture. Plants 2021, 10, 185. [Google Scholar] [CrossRef]
- Caplan, D.; Dixon, M.; Zheng, Y. Optimal Rate of Organic Fertilizer during the Flowering Stage for Cannabis Grown in Two Coir-Based Substrates. HortScience 2017, 52, 1796–1803. [Google Scholar] [CrossRef]
- Caplan, D.; Stemeroff, J.; Dixon, M.; Zheng, Y. Vegetative Propagation of Cannabis by Stem Cuttings: Effects of Leaf Number, Cutting Position, Rooting Hormone, and Leaf Tip Removal. Can. J. Plant Sci. 2018, 98, 1126–1132. [Google Scholar] [CrossRef]
- Campbell, L.G.; Naraine, S.G.U.; Dusfresne, J. Phenotypic Plasticity Influences the Success of Clonal Propagation in Industrial Pharmaceutical Cannabis Sativa. PLoS ONE 2019, 14, e0213434. [Google Scholar] [CrossRef]
- Rodríguez, H.; Gonzalez, T.; Selman, G. Expression of a Mineral Phosphate Solubilizing Gene from Erwinia Herbicola in Two Rhizobacterial Strains. J. Biotechnol. 2000, 84, 155–161. [Google Scholar] [CrossRef]
- Shehata, H.R.; Lyons, E.M.; Jordan, K.S.; Raizada, M.N. Relevance of in vitro Agar Based Screens to Characterize the Anti-Fungal Activities of Bacterial Endophyte Communities. BMC Microbiol. 2016, 16, 8. [Google Scholar] [CrossRef]

| Seed-Borne Seedling Endophytes | Hemp Cultivars | Marijuana Cultivars | Flax | |||||||||||||
|---|---|---|---|---|---|---|---|---|---|---|---|---|---|---|---|---|
| Field | Field | Field | Field | Field | Field | Field | Field | Field | Indoor | Indoor | Indoor | Indoor | Indoor | Indoor | Field | |
| Bacterial Species | Altair | Alyssa | CAN 3797 | Canda | FIN34 | Grandi | Katani | LKCSD | X-59 | X-59 Gen 2 | Afghani | BC Big Bud | God’s Bud | God’s Pink | White Widow | Bethune |
| Bacillus aerius | ||||||||||||||||
| Bacillus circulans | ||||||||||||||||
| Bacillus ginsengihumi | ||||||||||||||||
| Bacillus inaquosorum | ||||||||||||||||
| Bacillus megaterium | ||||||||||||||||
| Bacillus stratosphericus | ||||||||||||||||
| Bacillus subtilis | ||||||||||||||||
| Bacillus velezensis | ||||||||||||||||
| Bacillus wiedmannii | ||||||||||||||||
| Bacillus zhangzhouensis | ||||||||||||||||
| Bacillus simplex | ||||||||||||||||
| Brevibacillus choshinensis | ||||||||||||||||
| Paenibacillus azotifigens | ||||||||||||||||
| Paenibacillus humicus | ||||||||||||||||
| Paenibacillus illinoisensis | ||||||||||||||||
| Paenibacillus mobilis | ||||||||||||||||
| Paenibacillus pabuli | ||||||||||||||||
| Paenibacillus polymyxa | ||||||||||||||||
| Paenibacillus senegalensis | ||||||||||||||||
| Paenibacillus sinopodophylli | ||||||||||||||||
| Paenibacillus taohuashanense | ||||||||||||||||
| Paenibacillus terreus | ||||||||||||||||
| Paenibacillus vulneris | ||||||||||||||||
| Paenibacillus yunnanensis | ||||||||||||||||
| Pantoea agglomerans | ||||||||||||||||
| Psychrobacter pulmonis | ||||||||||||||||
| Strain ID | Taxonomy | Accession | Host | Antagonizes |
|---|---|---|---|---|
| OKM96 | Bacillus inaquosorum | BC Big Bud | Marijuana | Alternaria |
| OKM115 | Bacillus subtilis | BC Big Bud | Marijuana | Alternaria, Fusarium |
| OKM121 | Bacillus subtilis | God’s Bud | Marijuana | Alternaria, Fusarium |
| OKM128 | Bacillus subtilis | CAN 3797 | Hemp | Alternaria, Fusarium, Penicillium |
| OKM141 | Bacillus velezensis | CAN 3797 | Hemp | Alternaria, Aspergillus, Fusarium, Penicillium |
| OKM147 | Paenibacillus polymyxa | Altair | Hemp | Alternaria, Aspergillus, Fusarium, Penicillium |
| OKM155 | Paenibacillus polymyxa | Katani | Hemp | Alternaria, Aspergillus, Fusarium, Penicillium |
| OKM162 | Bacillus subtilis | Grandi | Hemp | Alternaria, Fusarium |
| OKM163 | Bacillus subtilis | Altair | Hemp | Alternaria, Fusarium |
| OKM169 | Bacillus subtilis | LKCSD | Hemp | Alternaria, Fusarium |
| OKM170 | Paenibacillus polymyxa | FIN34 | Hemp | Alternaria, Aspergillus, Fusarium, Penicillium |
| OKM173 | Bacillus subtilis | FIN34 | Hemp | Alternaria, Fusarium |
| OKM186 | Bacillus subtilis | Alyssa | Hemp | Alternaria, Fusarium |
Publisher’s Note: MDPI stays neutral with regard to jurisdictional claims in published maps and institutional affiliations. |
© 2022 by the authors. Licensee MDPI, Basel, Switzerland. This article is an open access article distributed under the terms and conditions of the Creative Commons Attribution (CC BY) license (https://creativecommons.org/licenses/by/4.0/).
Share and Cite
Dumigan, C.R.; Deyholos, M.K. Cannabis Seedlings Inherit Seed-Borne Bioactive and Anti-Fungal Endophytic Bacilli. Plants 2022, 11, 2127. https://doi.org/10.3390/plants11162127
Dumigan CR, Deyholos MK. Cannabis Seedlings Inherit Seed-Borne Bioactive and Anti-Fungal Endophytic Bacilli. Plants. 2022; 11(16):2127. https://doi.org/10.3390/plants11162127
Chicago/Turabian StyleDumigan, Christopher R., and Michael K. Deyholos. 2022. "Cannabis Seedlings Inherit Seed-Borne Bioactive and Anti-Fungal Endophytic Bacilli" Plants 11, no. 16: 2127. https://doi.org/10.3390/plants11162127
APA StyleDumigan, C. R., & Deyholos, M. K. (2022). Cannabis Seedlings Inherit Seed-Borne Bioactive and Anti-Fungal Endophytic Bacilli. Plants, 11(16), 2127. https://doi.org/10.3390/plants11162127
